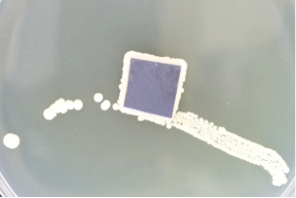

We did several experiments to verify the effectiveness of our ultrasonic cleaner. In one of the experiments, average size of 2.25 squared centimetre silicon wafer chips were contaminated with pig blood for a whole night before they were put into ultrasonic bath containing 300 ml tap water (at room temperature 21.8 degree C) and cleaned at different time durations of 90s, 180s and 280s. Figure 5 (a) and (b) shows before and after cleaning for 180 s. However, the results are inconclusive because the visual inspection at removal of contamination does not verify how much the chip is cleaned at microscopic level.
Cleaning solution is an important factor in ultrasonic cleaning. There are several effective ultrasonic-cleaning chemicals. However, taking into consideration scarce medical supplies in remote underdeveloped regions, we did a few experiments using normal household and kitchen products, cheaply available around us. We conducted a systematic controlled experiment at the laboratory of Department of Life Sciences, Imperial College London, under the supervision of Chief Teaching Technician, Mr. David Featherbe. Silicon chips are equally contaminated by unclean fingers. They are later cleaned by immersing in saline water (3.5% and 10%), vinegar, ethanol and autoclaved water in ultrasonic bath at 42 kHz for 3 min. Figure 6, 7, 8 and 9 are taken after 5 days of the experiments. Detailed experimental procedure can be found under Appendix A, Section 5.
From this experiment (refer to Figure 6, 7, 8, 9), we can conclude that ultrasonic cleaning with just water is not effective. However, ultrasonic cleaning with the right cleaning solution can effectively clean the target object at microscopic level. However, a few conditions have to be considered here. First, experiments here are applicable only to normal human body flora and fungal flora, and not conclusive of other deadly bacteria or viruses (which needs further experiments). Second, the target object chosen to be cleaned are ideally flat and uncomplicated. Therefore, experimental results can only verify for the most idealistic situations, whereas realistically, complex surface nature of surgical instruments, needles and syringes have to be considered and needs further experiments.


Figure 5 (a) Before cleaning (left), (b) after cleaning for 180 s (right)


Figure 6. (a) Contaminated silicon chip before cleaning (far left). (b) After submerging in autoclaved water (400ml, at 21.8˚ C, 180s) after being cleaned by ultrasonic at 42 kHz (far right).

Figure 7. (a) Silicon chip after submerging in 10% saline (400ml, at 21.8˚ C, 180s) without being cleaned by ultrasonic (centre). (b) After submerging in 10% saline (400ml, at 21.8˚ C, 180s) after being cleaned by ultrasonic at 42 kHz (far right).


Figure 8. (a) Silicon chip after submerging in white wine vinegar (220ml, at 21.8˚ C, 180s) without being cleaned by ultrasonic. (c) After submerging in white wine vinegar (220ml, at 21.8˚ C, 180s) after being cleaned by ultrasonic at 42 kHz.


Figure 9. (a), (b) Silicon chip after submerging in 70% ethanol (220ml, at 21.8˚ C, 180s) after being cleaned by ultrasonic at 42 kHz.